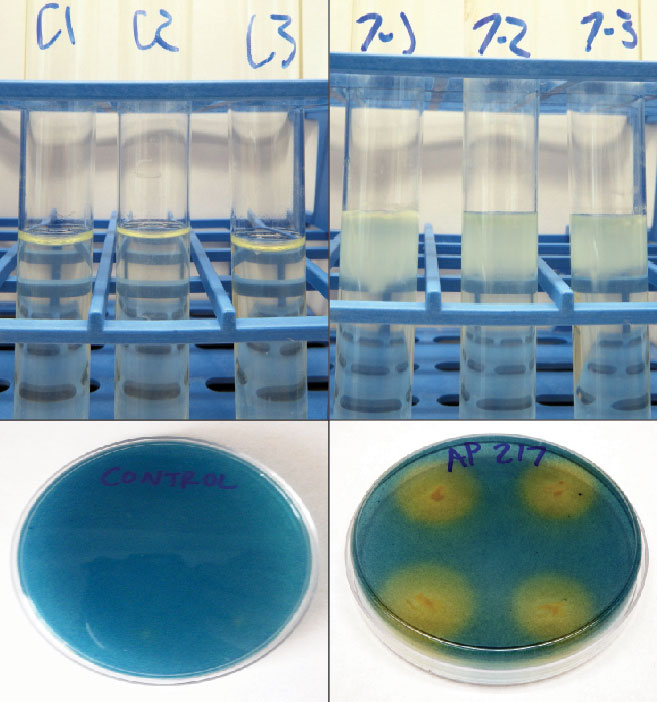

Manipulating microbial ecology
Water and fertilizer use for turfgrass and horticultural commodities is a local, state and national concern for these industries. Water availability for irrigation has decreased in recent years because of greater demands from agriculture, industry, domestic uses and climate variability. Additionally, increasingly stringent state and federal regulations often limit water or chemical inputs for managing amenity crops, including turfgrass.
These catalysts are driving the need for and adoption of management strategies to conserve water or increase water-use efficiency. However, new biological technologies in development may further advance reduced inputs in turfgrass. Development and integration of these biologicals can positively change the ability of grasses to tolerate abiotic and biotic stresses while reducing chemical and water needs. Coupling these biological innovations with environment stewardship goals could allow for the maintenance of high-quality turfgrasses under adverse conditions with limited resource input.
Incorporation of plant biostimulants or biofertilizers into management practices are possible methods of maintaining high-quality turfgrasses. European and North American definitions of biostimulants vary because of the wide array of substances classified as biostimulants. For regulatory purposes, distinctions typically are made between biostimulants and biopesticides based on their agricultural use.
Biostimulants and biopesticides
Biostimulants in North America are defined as substances, including microorganisms, that when applied to plants, seeds and soil may integrate applied nutrients or provide benefits to plant development. They are not considered plant nutrients and so cannot make nutritional claims or guarantees. Do not misinterpret this lack of claims or guarantees as a lack of research. Reported impacts of biostimulants on plants include enhanced growth and development, improved nutrient uptake and efficiency or reduced nutrient losses and improvement in soil structure, function or performance. Previous work with biostimulants in turfgrass focused on seaweed extracts, plant hormones and humic acid, however, living biostimulants that manipulate or augment soil microbes are gaining popularity.
Living biostimulants colonize and persist in plants or soil, yielding growth benefits, and in some cases, negative impacts on insect pests and nematodes. For example, Bacillus sphaericus induces growth promotion and stress mitigation in many crops, including turfgrasses (hybrid bermudagrasses and tall fescue). It also is a larvicide against mosquitoes and an ovipositional deterrent against the fall armyworm, which complicates the distinction between a biostimulant and a biopesticide.
Figure 1 Top: Ability for nitrogen fixation by rhizobacteria is indicated by pellicle (white membrane) formation on NFb media (left) by Bacillus pumilus AP 7 compared to control (uninoculated) media (right). Bottom: Ability of siderophore production by bacteria is indicated by the orange halo from single colonies of Brevibacillus brevis AP 217 plated on CAS media (right) compared to control (uninoculated) (left).
The most studied have been living biostimulants, including arbuscular mycorrhizal fungi (AMF) and bacteria called plant growth-promoting rhizobacteria (PGPR). These living biostimulants are epiphytic (capable of living on plant surfaces), endophytic (capable of living within the plant tissue) or both.
Researchers isolate and culture these non-pathogenic microbes from soil, plants, plant residues, water and composted manures. Once isolated, we can inoculate soil, whole plants or seeds with these microorganisms to observe plant responses. Soil microbial communities are intimately associated with plants, influencing health, biomass accumulation, soil quality and nutrient availability and acquisition. The microbial communities in the rhizosphere (the layer of soil that is influenced by the plant root) are highly specialized and influenced by climate, soil type and characteristics and ground cover.
Certain microbes, when present or dominant, can induce changes in plants and influence plant/microbe interactions. Changes in plant growth resulting from inoculation with PGPR may result from nitrogen fixation, phosphate solubilization, siderophore production or upregulation of signal pathways in plants (Figure 1). PGPR have been linked to drought mitigation through priming plant-signaling defenses that alter plant-water regulation, use and efficiency; production of larger, more explorative root systems; synthesis of phytohormones (cytokinins, auxins, gibberellins, ethylene, etc.), or by the production of secondary metabolites.
In its infancy
While neither the bacteria nor its effects on plants is new, research with PGPR as a living biostimulant in turfgrass is in its infancy. Interactions of bacteria with plants may lay the groundwork for novel solutions to several different issues in turfgrass management. PGPR are non-pathogenic, beneficial, free-living soil- and root-inhabiting bacteria that colonize seeds and roots in the rhizosphere. The rhizosphere has a greater density of organic carbon and bacteria than the rest of the bulk soil, which influences the composition of root exudates and metabolites that can be used as plant nutrients.
Because the rhizosphere bacterial community is richer than bulk soil, competition exists between microbes for limited soil nutrients and space for colonization on the root. To have a positive impact on the plant, inoculants must have high bacterial concentrations and be formulated for the stability of these bacteria to compete and augment the soil microbial community once they are applied. Successful rhizobacterial inoculants must survive through formulation and inoculation, then multiply and colonize the developing root system once applied. In our turfgrass work so far, rhizobacterial inoculants have been shown to consistently increase root biomass in several bermudagrasses (Coastal, Tifway, LaPaloma, Yukon) and endophyte-free tall fescue (KY 32). They also may mediate plant/microbe/insect interactions with several turfgrass pests (fall armyworms, grubs and mole crickets) while altering water regulations during drought stress, compared to untreated and fertilized grasses.
Abiotic and biotic conditions can change frequently, presenting challenges that plants must overcome. To deal with this, plants engage sophisticated physiological, cellular, biochemical and molecular responses to maintain homeostasis under harsh conditions.
Turfgrass exposure to abiotic stress decreases aesthetic quality, functionality and playability. Environmental stress in grasses often results from temperature, water and light stress, or from poor soil quality. Drought, salinity and temperature stresses alter plant responses, limiting growth, productivity and survival.
Turfgrass response to stress at the whole plant or cellular level is vital for the development of new grass cultivars and for the incorporation of novel technologies into management practices. Living biostimulants like PGPR have an advantage over traditional breeding in that they can be applied responsively to stress. Drought, for example, is unpredictable and temporary. Application of PGPR can provide benefits in the same season regardless of cultivar.

Figure 2 Drought recovery of LaPaloma bermudagrass in 100 percent sand after 21 days without water under greenhouse conditions. Top left: Blend 20 plus 50 percent nitrogen after one-week recovery. Top right: Blend 20 plus 50 percent nitrogen after three weeks of recovery. Top (eight) pots in each container were retreated post drought, bottom (eight) plants were not retreated. Bottom: All LaPaloma treatments during drought recovery. Front left to right: Blend 20, control, nitrogen; Back left to right: Blend 20 plus 50 percent nitrogen, 50 percent nitrogen.
Our lab recently has evaluated PGPR for drought interactions, mitigation and recovery with three bermudagrass cultivars (Tifway, LaPaloma and Yukon). Differences between rhizobacterial inoculants (blends) as well as differences between bacteria play vital roles in stress mitigation in bermudagrass (Figure 2).
Furthermore, we are exploring the soil microbial community for new bacteria. In the summer of 2016, an extreme drought occurred in Alabama, providing the opportunity to sample amenity turfgrasses, native grasses and weeds that maintained desirable physiological characteristics. The sampling of the plants led to the isolation of 604 bacterial strains that may be associated with drought tolerance and mitigation in grasses.

Figure 3 Mean (±SEM) log populations of Bacillus pumilus AP 7 mixed with bifenthrin, (high and low label rate), fipronil (high and low label rate), imidacloprid and imidacloprid and clothianidin over two weeks showed the population remained stable in the presence of the insecticides.
Products marketed with PGPR are formulated as single species of bacteria or as blends of multiple species or strains. The products may be available as a liquid or granule and are compatible with most chemicals already used. Studies monitored the stability of the bacterial populations mixed with neonicotinoids, phenypyrazole and pyrethroid insecticides over two weeks (Figure 3) and showed the population remained stable in the presence of the insecticides.
The bacteria often are formulated with a complement of plant nutrients that aid in bacterial growth and population longevity. For example, Bayer Environmental Sciences introduced Nortica, Bacillus firmus, a single species biofertilizer (0.1 lb. N/1,000 sq. ft.; 14-0-21) and biopesticide granular product for enhanced growth and nematode control in turfgrass. Recent research tracked the epiphytic and endophytic colonization and populations of non-commercial rhizobacteria under field conditions applied to common bermudagrass in a loamy sand over a 12-week period (Figure 4) and showed rhizobacteria colonization for 12 weeks. Beyond the compatibility with fertilizers and insecticides, PGPR (Bacillus subtilis) have been linked to a 38 percent to 65 percent increase in root biomass and increased uptake and efficiency of a neonicotinoid (thiamethoxam) in corn seedlings. The increase in use efficiency could lead to lower use rates of systemic pesticides.

Figure 4 Bacillus pumilus AP 7 rifampicin mutant mean (± SEM) log populations CFU/g (0.035 oz.) of tissue in common bermudagrass (Cynodon dactylon) grown under field conditions in a Marvyn loamy sand soil (pH 7.3). Grasses were treated with bacterial populations of 1.98 x 108 CFU/oz. at a rate of 16.9 oz. of bacteria per 10.76ft2. Applications were followed by 0.5 inch of water. Populations sampled the rhizosphere (external roots and soil) and endophytic (internal roots and shoots) colonization for 12 weeks and showed rhizobacteria colonization for 12 weeks.
While research with PGPR is relatively new in turfgrass, the biostimulant market is growing, with an expected market value of $2.2 billion in 2018. On Sept. 14, 2017, Bayer announced a $100-million partnership with Ginkgo Bioworks, a microbe genetic engineering company that markets endophytic bacteria for nitrogen fixation. The compatibility of microbes with current technology and recent insights into benefits for crops and grasses demonstrates the ability and need to incorporate these technologies into turf management practices.
PGPR, N Fixation and siderophore production
Bacteria that fix nitrogen can increase plant growth, nutrient efficiency and uptake. The increase in uptake can lead to lower fertilizer needs. Further, endophytic bacteria that fix nitrogen in planta could be incorporated into future grass germplasms. Qualitative nitrogen fixation activity of bacteria was evaluated in a nitrogen-free semisolid media (NFb) in the laboratory. Single bacterial colonies were introduced to the NFb semisolid media and monitored for 48 hours to 72 hours. This allows us to determine if bacteria can fix nitrogen in an oxygen gradient that is comparable to internal plant environments. Growth characteristics of a pellicle (a thin membrane or film) in the media indicate nitrogen fixation.
Siderophores bind iron and other nutrients for plant use. They have been linked to plant growth promotion, increased chlorophyll content, disease suppression and bioremediation of heavy metal soils. Qualitative siderophore production of bacteria was evaluated with Chrome azurol S (CAS) agar in the laboratory. Bacteria were grown on growth media for 24 hours, and single colonies were transferred to quadrants on the CAS media. Orange halos growing around the bacteria colonies confirmed siderophore production by the bacteria after 48 hours to 72 hours.
PGPR and insecticide compatibility
Bacteria that increase plant growth and pesticide efficiency could allow lower use rates. For commercial development, bacteria that are not negatively affected by exposure to pesticides in product or soil must be identified. Bacterial strains from multiple genera with known populations (minimum of 1 x 108 colony forming units (CFU)/ml (0.03 oz.)) were evaluated individually for their compatibility with commonly used turfgrass insecticides. Bacteria were individually mixed in 50 ml (1.69 oz.) centrifuge tubes with three different insecticide classes (neonicotinoids, phenylpyrazole, pyrethroid) based on label rates (high and low, when applicable). Samples were taken from each solution after one hour, 24 hours, one week and two weeks. Samples were then transferred to glass tubes with sterile water and serially diluted. Samples were transferred to growth media for 24 hours before populations were estimated based on bacterial colony counts.
Results show the bacterial populations from the Bacillus pumilus AP 7 samples demonstrating compatibility with common insecticides. These data trends in population stability were typical of all bacteria tested. Bacterial populations are graphed as their log CFU/ml, for example a log value of 8 is equal to 1 x 108.
PGPR and drought tolerance
Traditional turfgrass breeding alone has not solved the challenges and unpredictability of drought. Grasses are selected for their aesthetics and playability. The incorporation of microbes that improve stress tolerances and that can be selectively applied when needed offers advantages for management.
Green studies were designed to evaluate drought responses of bacteria-treated, bacteria-treated with 50 percent nitrogen, 50 percent nitrogen, fully fertilized and untreated bermudagrasses with varying drought tolerances LaPaloma (moderately tolerant) and Yukon (susceptible). In this study, we used Blend 20, a mixture of three bacterial strains (Bacillus pumilus AP 7, Bacillus pumilus AP 18 and Bacillus sphaericus AP 282). Grasses were established for a month, and then treated for five weeks before drought exposure for three weeks.
Experiments assessed changes in chlorophyll, relative water content, electrolyte leakage (pre, during and post-drought) and root biomass, length, surface area and volume. After the drought period, grasses recovered for three weeks. During recovery, half of the potted grasses had treatments reapplied and the other half only recovered with water to determine if reapplication was necessary. Differences in drought responses were related to treatment and cultivar. The reapplication of treatments was necessary to aid in recovery. Grasses treated with PGPR plus 50 percent nitrogen suffered less damage during drought stress, recovered more quickly and had the largest roots.
Work in our lab suggests that PGPR may positively influence turfgrass management by inducing changes and increasing tolerance to abiotic and biotic stress. There are fewer PGPR products available for use in amenity grasses than for food or fiber crops. However, as this and previous work demonstrates the utility of PGPR for plant growth promotion and IPM, we anticipate products containing these beneficial microbes to become more widely available.
Murphey Coy is a Ph.D. candidate, and David Held, Ph.D., is an entomologist in Entomology and Plant Pathology at Auburn University. You may reach Murphey at rmc0023@tigermail.auburn.edu for more information.
References
Bashan, Y., L.E. de-Bashan, S.R. Prabhu, J-P. Hernandez. 2014. Advances in plant-growth promoting bacterial inoculant technology: formulations and practical perspectives (1998-2013). Plant Soil. 378:1-33.
Calvo, P. L. Nelson, and J.W. Kloepper. 2014. Agricultural uses of plant biostimulants. Plant Soil. 383:3. DOI: 1 0.1007/s11104-014-2131-8.
Coy, R.M., D.W. Held, and J.W. Kloepper. 2014. Rhizobacterial inoculants increase root and shoot growth in ‘Tifway’ hybrid bermudagrass. J. Environ. Hort. 32:149-154.
Coy, R.M., D.W. Held, and J.W. Kloepper. 2017. Bacterial inoculant treatment of bermudagrass alters ovipositional behavior, larval and pupal weights of the fall armyworm, Spodoptera frugiperda (Lepidoptera: Noctuidae). Environmental Entomology. 46: 831-838.
Du, H., Z. Wang, W. Yu, and B. Huang. 2012. Metabolic responses of hybrid bermudagrass to short-term and long-term drought stress. J. Amer. Soc. Hort Sci. 137:411-420.
Hu, L., Z. Wang, and B. Huang. 2009. Photosynthetic responses of bermudagrass to drought stress associated with stomatal and metabolic limitations. Crop Sci. 49: 1902-1909.
Gagné-Bourque, F., B.F. Mayer, J-B. Charron, H. Vali, A. Bertrand, and S. Jabaji. 2015. Accelerated growth rate and increased drought stress resilience of the model grass Brachypodium distachyon colonized by Bacillus subtilis B26. PLoS ONE 10(6): e0130456. DOI:10.1371/journal. pone.0130456.
Grayston, S.J., D. Vaughan, and D. Jones. 1997. Rhizosphere carbon flow in trees, in comparison with annual plants: the importance of root exudation and its impact on microbial activity and nutrient availability. Appl. Soil. Ecol. 5: 29-56.
Kaushal, M., and S.P. Wani. 2016. Rhizobacterial-plant interactions: strategies ensuring plant growth promotion under drought and salinity stress. Agric. Ecosys. Environ. 231: 68-78.
Lacey L.A. 2007. Bacillus thuringiensis serovariety israelensis and Bacillus sphaericus for mosquito control. J Am Mosq Control Assoc 23: 133-163.
Myresiotis, C.K., Z. Vryzas, and E. Papadopoulou-Mourkidou. 2015. Effect of specific plant-growth promoting rhizobacteria (PGPR) on growth and uptake of neonicotinoid insecticide thiamethoxam in corn (Zea mays L.) seedlings. Pest Manag. Sci. 71: 1258-1266.
Sayyed, R.Z., P.R. Patel, and M.S. Reddy. Role of PGPR in the bioremediation of heavy metal ions, and plant growth-promotion of wheat and peanut grown in heavy metal contaminated soils. In Recent Advances in biofertilzers and biofungicides for sustainable agriculture, ed. by M.S. Reddy, R.O. Ilao, P.S. Faylon, W.D. Dar, and W.D. Batchelor, Cambridge Scholars Publishing, pp. 105-120.
Sharma, A., B.N. Johri, A.K. Sharma, and B.R. Glick. 2003. Plant growth-promoting bacterium Pseudomonas sp. strain GRP3 influences iron acquisition in mung bean (Vigna radiata L. Wilzeck). Soil Biol. Biochem. 35: 887-894.
Walker, T.S., H.P. Bais, E. Grotewold, J.M. Vivanco. 2003. Root exudation and rhizosphere biology. Plant Physiol. 132: 44-51.
Photos: Murphey Coy